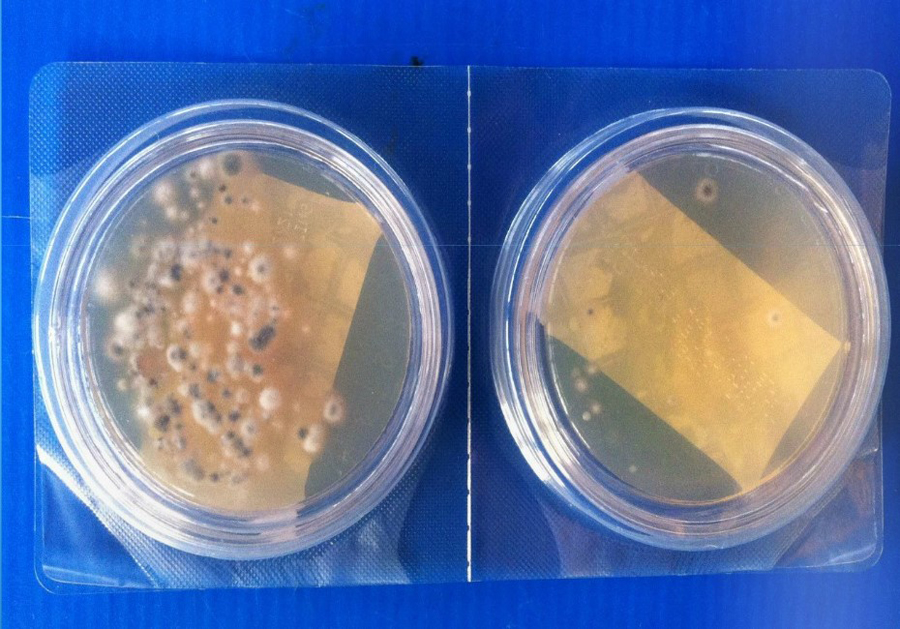

Sicurezza e benessere di spazi e ambienti di vita sono condizioni da osservare e mantenere con estrema cura. Quotidianamente gli agenti patogeni negli ambienti indoor trasmettono malattie agli organismi sani.
Come attuare una disinfezione ambientale efficace degli spazi di vita?
CleanSystem è la soluzione di Bg Service, per la sanificazione di ambienti indoor.
CleanSystem per la sanificazione degli ambienti indoor

Detersione e pulizia attraverso prodotti di mercato non risolvono il problema,a volte possono persino contribuire al peggioramento della situazione ambientale. Per assicurare “rischio infettivo minimo”in ambienti di lavoro e di vita quotidiana c’è CleanSystem: la garanzia contro l’esposizione alle cariche batteriche.
Quali sono le attività di CleanSystem?
- Biodecontaminazione e anticontagio;
- Disinfezione certificata da virus h1n1 (influenza);
- Disinfezione ambientale antimicrobica;
- Purificazione dell’ariaeliminando efficacemente polveri, odori e pollini;
- Controllo delle infezioni trasmesse per via aerea.
CleanSystem, ovunque!
In qualsiasi ambiente CleanSystem è la soluzione efficace! Soprattutto in spazi dove le condizioni igieniche sono imprescindibili:
- Sale operatorie, camere bianche, studi e laboratori odontoiatrici.
- Impianti aeraulici (canalizzazioni aria).
- Impianti di termoventilazione (fan-coils, splits, unità di trattamento aria etc.).
- Mense di scuole, ospedali e locali aziendali.
- Ambienti indoor in genere con attrezzature e oggetti presenti al loro interno.
CleanSystem consiste nell’abbinamento tra macchinaClean Cube e Clean Neutral, disinfettante a base di perossido di idrogeno e acqua bio-osmotizzata. Né tossico né corrosivo, il prodotto erogato non crea umidità, è efficace contro virus e batteri, funghi e spore e indicato per qualsiasi superficie, oggetti e attrezzature presenti nello spazio. La sua azione in 15-20 minuti deve avvenire in assenza di persone, ma è di rapida degradazione e dissoluzione completa nell’aria; non crea depositi e non lascia residui perché biodegradabile oltre il 99%. Tutto secondo protocollo HACCP.
Sanificazione ambientale e disinfezione? Scegli CleanSystem di Bg Service.
Guarda il video e scopri quant’è efficace!
Richiedi Informazioni.
Se sei alla ricerca di un servizio professionale in tema di sanificazione canali aria, pulizia motori cappe, pulizia impianti fotovoltaici o sanificazioni ambientali, inviaci la tua domanda.
Il nostro staff è a tua disposizione per preventivi gratuiti e personalizzati o per una consulenza specifica.
Leggi il nostro Blog
Leggi qui le News e gli approfondimenti più popolari per argomento tra Sanificazione dei Canali Aria, Pulizia dei Motori Cappe Industriali e Pulizia degli Impianti Fotovoltaici
Impatto della qualità dell’aria sulla produttività aziendale e il benessere
La sanificazione ambienti indoor ha oggi un valore strategico per le aziende. Molte organizzazioni investono in tecnologia, arredi
Pulizia Pannelli Fotovoltaici a Brescia: Recupera Fino al 30% di Resa con la Manutenzione Professionale
Scopri perché le polveri sottili riducono l’efficienza dei pannelli fotovoltaici a Brescia e come la pulizia professionale migliora rendimento energetico.
Pulizia dei pannelli solari in aree con forte presenza di smog e polveri sottili
Intervenire con una pulizia anti-inquinamento sui pannelli solari specifica permette di mantenere stabile la resa annuale, prevenendo cali energetici e perdite economiche. Ne parliamo in questo articolo.




